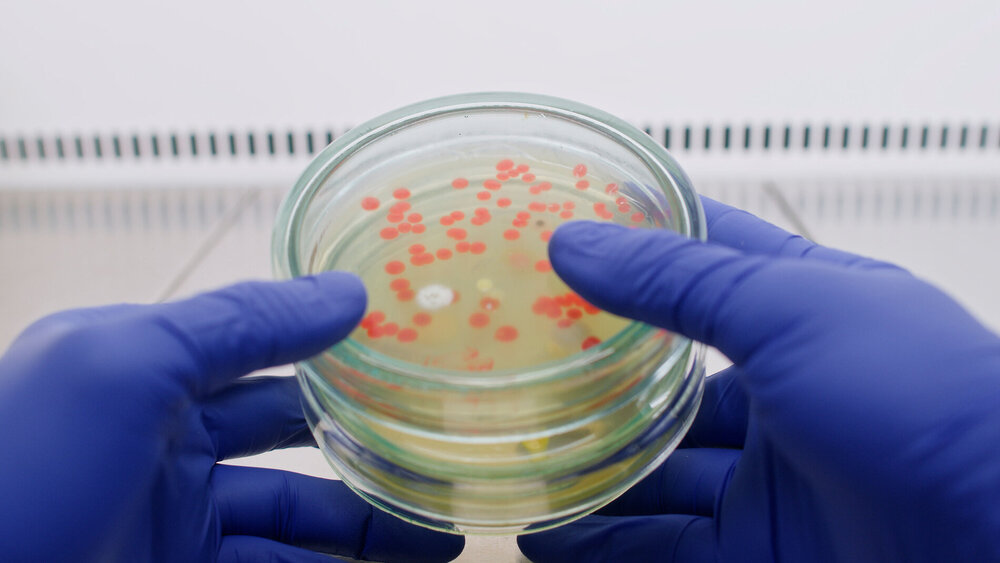

Fast 10.000 Menschen starben 2019 an antibiotikaresistenten Erregern
Am 14. August dieses Jahres wurde die Studie mit dem Titel „Antibiotikaresistenz-Belastungslandschaft in Deutschland im Jahr 2019: eine vergleichende Schätzung auf Länderebene“ im „Journal of Antimicrobial Chemotherapy – Antimicrobial Resistance“ veröffentlicht.
Mit ihrer Untersuchung wollten die Wissenschaftler nach eigenen Angaben die bisher umfassendste Sammlung von Schätzungen zur Belastung durch antimikrobielle Resistenzen (AMR) vor der Corona-Pandemie für Deutschland vorlegen.
Die Forschenden schätzten die Todesfälle und behinderungsbereinigten Lebensjahre (DALYs) aufgrund von antimikrobiellen Resistenzen (AMR) für 23 bakterielle Krankheitserreger und 88 Erreger-Wirkstoff-Kombinationen in Deutschland im Jahr 2019. Sie erfassten dabei Todesfälle, die auf AMR zurückzuführen sind (die nicht eingetreten wären, wenn die Erreger nicht resistent gewesen wären) und Todesfälle im Zusammenhang mit AMR (Fälle, in denen Infektionen mit einem antibiotikaresistenten Erreger zwar Todesursache war, eine betroffene Person vermutlich aber auch dann gestorben wäre, wenn der Erreger keine Resistenz aufgewiesen hätte).
Dabei fanden die Forscher heraus: Die Gesamtmortalitätslast und die DALYs im Zusammenhang mit AMR betrugen 45.692 (31.281 bis 64.591) Todesfälle und 752.697 (500.313 bis 1.076.187) DALYs. Die Gesamtbelastung durch AMR betrug 9.648 (6.520 bis 13.918) Todesfälle und 159.032 (105.021 bis 232.459) DALYs.
Infektionen der Blutbahn, der Atemwege und des Bauchraums trugen demnach am meisten zur tödlichen AMR-Belastung bei. Die häufigsten Erreger, die für AMR-assoziierte Todesfälle verantwortlich waren, waren Escherichia coli, Staphylococcus aureus, Enterococcus faecium, Klebsiella pneumoniae und Pseudomonas aeruginosa.
E. coli, die gegen Beta-Lactam/Beta-Lactamase-Inhibitoren und Aminopenicillin resistent sind, waren die häufigsten Erreger-Wirkstoff-Kombinationen, die jeweils zu AMR-bedingten beziehungsweise mit AMR assoziierten Todesfällen führten.
Große Herausforderung für das Gesundheitswesen
„Die hohen Resistenzraten und die erhebliche Gesundheitsbelastung machen AMR zu einer ernstzunehmenden Herausforderung für die öffentliche Gesundheit in Deutschland und unterstreichen die Notwendigkeit, gezielte Präventions- und Kontrollmaßnahmen gegen wichtige Erreger-Wirkstoff-Kombinationen weiter zu verstärken“, schreibt das Forscherteam.